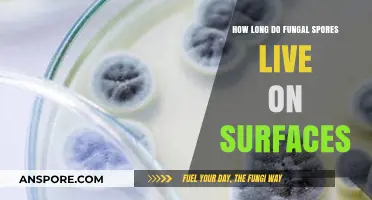
Fungal Spores Survival: How Long Do They Live on Surfaces?

Dry spores are renowned for their remarkable resilience, capable of surviving in harsh conditions for extended periods. These microscopic structures, produced by fungi, bacteria, and some plants, are designed to endure desiccation, extreme temperatures, and other environmental stresses. The longevity of dry spores varies widely depending on the species and environmental factors, but some can remain viable for decades, centuries, or even millennia under favorable conditions. This durability allows them to persist in soil, water, and air, waiting for optimal conditions to germinate and grow. Understanding how long dry spores last is crucial for fields such as agriculture, medicine, and environmental science, as it impacts disease control, food preservation, and ecosystem dynamics.
| Characteristics | Values |
|---|---|
| Survival Time in Dry Conditions | Can last from a few years to decades, depending on species and environment |
| Temperature Resistance | Tolerant to extreme temperatures, both hot and cold |
| Humidity Tolerance | Can survive in low-humidity environments |
| UV Radiation Resistance | Resistant to UV radiation, though prolonged exposure may reduce viability |
| Chemical Resistance | Resistant to many chemicals, including disinfectants |
| Desiccation Tolerance | Highly tolerant to desiccation (drying out) |
| Species Variability | Survival time varies widely among different spore-producing organisms |
| Examples of Longevity | Bacillus anthracis spores can survive for decades; fungal spores like Aspergillus can last years |
| Revival Conditions | Can revive and germinate when exposed to favorable conditions (moisture, nutrients) |
| Common Environments | Found in soil, dust, and on surfaces, often surviving in dormant states |
Explore related products
What You'll Learn
- Storage Conditions Impact: Temperature, humidity, light, and container type affect dry spore longevity significantly
- Species Variability: Different spore types (e.g., fungi, bacteria) have varying survival durations
- Desiccation Tolerance: Some spores survive decades in dry states due to natural resistance
- Environmental Factors: Exposure to air, chemicals, or UV light can shorten spore lifespan
- Revival Potential: Dormant spores can remain viable for years, reactivating under favorable conditions

Storage Conditions Impact: Temperature, humidity, light, and container type affect dry spore longevity significantly
Dry spores, when stored under optimal conditions, can remain viable for decades, even centuries. However, their longevity is not a given; it hinges critically on storage conditions. Temperature, humidity, light exposure, and container type each play a distinct role in preserving or degrading spore viability. Understanding these factors is essential for anyone handling spores, whether for scientific research, agriculture, or preservation.
Temperature Control: The Cold Truth
Spore survival is highly temperature-sensitive. Low temperatures slow metabolic activity and reduce degradation, making refrigeration or freezing ideal. For instance, storing spores at -20°C can extend their viability to 50 years or more, while room temperature (20-25°C) may limit survival to a few years. Extreme heat, above 50°C, can denature proteins and destroy spores within hours. For home storage, a consistently cool environment, such as a refrigerator, is recommended. Avoid frequent temperature fluctuations, as these can stress spores and accelerate deterioration.
Humidity Management: The Moisture Paradox
Dry spores are resilient, but humidity can reintroduce moisture, triggering premature germination or fungal growth. Relative humidity (RH) should be kept below 40% to prevent absorption of water vapor. Silica gel packets are an effective tool to maintain low humidity in storage containers. Conversely, overly dry conditions (below 20% RH) can cause desiccation damage. For long-term storage, desiccants like calcium chloride or molecular sieves can help strike the right balance. Regularly monitor humidity levels with a hygrometer to ensure consistency.
Light Exposure: The Silent Degradation Factor
Light, particularly UV radiation, can degrade spore DNA and reduce viability. Spores stored in clear containers or exposed to sunlight are at higher risk. Opaque or amber-colored containers block harmful wavelengths, providing a protective barrier. For added safety, store spores in a dark cabinet or wrap containers in aluminum foil. While light damage is slower than temperature or humidity effects, cumulative exposure can significantly shorten spore lifespan.
Container Selection: Material Matters
The choice of container material is often overlooked but crucial. Glass vials with airtight seals are superior to plastic, as they prevent moisture exchange and chemical leaching. Plastic containers, especially those made of PVC, can degrade over time and release harmful compounds. For bulk storage, stainless steel canisters with rubber gaskets offer durability and protection. Always clean containers with sterile alcohol before use to eliminate contaminants. Label containers with storage dates and conditions for future reference.
By meticulously controlling temperature, humidity, light, and container type, dry spore longevity can be maximized. These storage conditions are not independent; they interact to create an environment that either preserves or compromises spore viability. For example, combining low temperature, controlled humidity, light protection, and proper container selection can extend spore life to several decades. Whether for scientific research or personal use, investing time in optimizing storage conditions yields significant returns in spore preservation.
Do Spores Spread on Death? Unveiling the Fungal Afterlife Mystery
You may want to see also

Species Variability: Different spore types (e.g., fungi, bacteria) have varying survival durations
Dry spores, those resilient microscopic survivalists, showcase a remarkable diversity in longevity across species. Fungal spores, for instance, are champions of endurance, with some species like *Aspergillus* and *Penicillium* persisting for decades in dry conditions. These spores owe their longevity to robust cell walls composed of chitin and other polymers, which shield their genetic material from environmental stressors. In contrast, bacterial spores, such as those of *Bacillus anthracis* (the causative agent of anthrax), can survive for centuries under optimal conditions. Their durability is attributed to a multilayered protective coat and minimal metabolic activity, allowing them to withstand extreme temperatures, radiation, and desiccation.
Understanding the survival durations of different spore types is crucial for industries like food safety, healthcare, and environmental management. For example, fungal spores in stored grains can remain viable for years, posing a risk of mycotoxin production if conditions become favorable for growth. Similarly, bacterial spores in soil or on surfaces can contaminate medical equipment or food processing facilities, leading to outbreaks if not properly sterilized. Practical tips for mitigating spore survival include maintaining low humidity levels, as many spores require moisture to germinate, and using heat or chemical treatments to destroy their protective structures.
A comparative analysis reveals that while fungal and bacterial spores share a common strategy of dormancy, their survival mechanisms differ significantly. Fungal spores often rely on environmental cues like temperature and nutrient availability to trigger germination, whereas bacterial spores are more resistant to harsh conditions due to their thicker, more complex coats. This variability underscores the need for species-specific control measures. For instance, fungal spores may be effectively managed through ventilation and dehumidification, while bacterial spores may require autoclaving or spore-specific disinfectants like hydrogen peroxide vapor.
Instructively, when dealing with spore contamination, it’s essential to identify the species involved to tailor your approach. For fungal spores in indoor environments, regular cleaning with HEPA-filtered vacuums and mold-inhibiting agents can prevent accumulation. In healthcare settings, bacterial spores demand more aggressive measures, such as steam sterilization at 121°C for 15–30 minutes or the use of sporicidal chemicals like chlorine dioxide. Dosage and duration of treatments must be precise; for example, chlorine dioxide at 1,000 ppm is effective against *Clostridium difficile* spores after 60 minutes of exposure.
Finally, the takeaway is clear: species variability in spore survival demands a nuanced approach to management. Whether you’re safeguarding food supplies, sterilizing medical instruments, or controlling indoor air quality, recognizing the unique characteristics of fungal, bacterial, and other spore types is key. By leveraging this knowledge, you can implement targeted strategies that minimize risks and maximize effectiveness, ensuring that these microscopic survivors remain dormant—or are eliminated entirely—in the environments you manage.
Rhizopus Sporulation: Understanding How This Fungus Multiplies Through Spores
You may want to see also

Desiccation Tolerance: Some spores survive decades in dry states due to natural resistance
Spores, the resilient reproductive units of certain fungi, bacteria, and plants, exhibit an extraordinary ability to withstand desiccation, enabling them to survive in dry states for decades. This phenomenon, known as desiccation tolerance, is a natural resistance mechanism that allows spores to endure extreme environmental conditions, such as low humidity and high temperatures. For instance, studies have shown that bacterial spores, like those of *Bacillus subtilis*, can remain viable for over 50 years in dry environments, while fungal spores, such as those of *Aspergillus* species, have been reported to survive for several decades under similar conditions.
The key to this remarkable survival lies in the spore's ability to enter a state of metabolic dormancy, reducing its water content to as low as 1-10% of its dry weight. This process, coupled with the production of protective molecules like trehalose and dipicolinic acid, safeguards the spore's cellular structures and DNA from damage. Trehalose, a disaccharide, stabilizes membranes and proteins, while dipicolinic acid, found in bacterial spores, chelates metal ions that could otherwise catalyze harmful reactions. These adaptations enable spores to withstand not only desiccation but also other stressors like radiation and extreme temperatures.
From a practical standpoint, understanding desiccation tolerance has significant implications for various fields. In agriculture, for example, fungal spores that survive dry conditions can contaminate stored grains, leading to crop losses. Implementing proper storage practices, such as maintaining low humidity levels (below 65%) and regular monitoring, can mitigate this risk. In the pharmaceutical industry, desiccation-tolerant spores pose challenges in sterilization processes, as they can survive conventional methods like autoclaving. Here, specialized techniques, such as dry heat sterilization at 160°C for 2 hours, are necessary to ensure complete spore inactivation.
Comparatively, desiccation tolerance in spores contrasts sharply with the vulnerability of most other life forms to water loss. While vegetative cells of bacteria and fungi typically perish within hours or days in dry conditions, spores can persist for years or even centuries. This disparity highlights the evolutionary advantage of sporulation as a survival strategy. For instance, in arid environments like deserts, spore-forming organisms dominate microbial communities, outcompeting less resilient species. This adaptability underscores the importance of spores in ecological resilience and their potential applications in biotechnology, such as in the development of drought-resistant crops.
In conclusion, desiccation tolerance in spores is a fascinating example of nature's ingenuity, enabling these microscopic entities to survive decades in dry states. By leveraging metabolic dormancy and protective molecules, spores defy environmental extremes, offering valuable insights for agriculture, medicine, and biotechnology. Whether combating spore contamination or harnessing their resilience, understanding this natural resistance mechanism is essential for addressing practical challenges and unlocking innovative solutions.
Mold Smell: Indicator of Airborne Spores and Health Risks Explained
You may want to see also
Explore related products

Environmental Factors: Exposure to air, chemicals, or UV light can shorten spore lifespan
Dry spores, renowned for their resilience, are not invincible. Environmental factors like air exposure, chemical contact, and UV light can significantly curtail their lifespan. Oxygen, a double-edged sword for life, accelerates spore degradation through oxidation. While spores can survive decades in vacuum-sealed environments, exposure to ambient air reduces their viability to months or even weeks, depending on humidity and temperature. For instance, *Bacillus anthracis* spores, notorious for their hardiness, degrade faster in open air compared to sealed containers, highlighting the role of oxygen in shortening their longevity.
Chemicals act as another formidable adversary to spore survival. Disinfectants like bleach (sodium hypochlorite) and hydrogen peroxide are particularly effective, with concentrations as low as 0.5% capable of inactivating spores within minutes. Even natural compounds, such as essential oils like tea tree oil or oregano oil, can disrupt spore membranes, though their efficacy varies. Industrial settings often use formaldehyde fumigation, which penetrates spore coats and denatures proteins, ensuring near-complete eradication. However, chemical exposure must be precise; overuse can harm surfaces or pose health risks, making it crucial to follow manufacturer guidelines.
UV light, a silent yet potent spore killer, mimics the sun’s germicidal effects. Short-wavelength UV-C light (254 nm) is especially lethal, damaging spore DNA and rendering them unable to germinate. Hospitals and laboratories use UV-C lamps to sterilize surfaces, with exposure times as short as 10–30 minutes achieving significant spore reduction. However, UV efficacy diminishes with distance and obstructions, requiring direct exposure for optimal results. Portable UV devices are increasingly popular for home use, but they are no substitute for thorough cleaning, as dust or shadows can shield spores from the light.
Practical strategies to exploit these environmental factors include combining them for synergistic effects. For example, pre-treating surfaces with UV light before applying disinfectants can enhance chemical penetration. In agricultural settings, exposing soil to sunlight (UV) and aerating it (air exposure) can reduce spore populations naturally. Homeowners can improve spore control by storing susceptible items in airtight containers, using UV-equipped air purifiers, and opting for chemical disinfectants with proven sporicidal activity. Understanding these interactions empowers targeted interventions, turning environmental factors from passive influences into active tools for spore management.
Are Spore Prints Illegal? Understanding Legal Boundaries in Mycology
You may want to see also

Revival Potential: Dormant spores can remain viable for years, reactivating under favorable conditions
Dry spores, often likened to nature’s time capsules, possess a remarkable ability to endure harsh conditions, lying dormant for years, even decades, only to revive when circumstances align. This resilience is not merely a biological curiosity but a survival strategy honed over millennia. For instance, *Bacillus anthracis* spores, responsible for anthrax, have been found viable in soil for up to 48 years, while fungal spores like those of *Aspergillus* can persist on surfaces for over a decade. Such longevity underscores the importance of understanding spore revival potential, particularly in contexts like healthcare, agriculture, and environmental management.
The key to spore revival lies in the precise combination of environmental factors—moisture, temperature, and nutrient availability. Spores are metabolically inactive, encased in a protective coat that shields their genetic material from damage. When conditions shift favorably, this protective barrier weakens, allowing water and nutrients to penetrate, triggering germination. For example, fungal spores often require humidity levels above 70% and temperatures between 20°C and 30°C to reactivate. Practical tip: In indoor environments, maintaining relative humidity below 60% can significantly reduce the risk of dormant spores awakening, particularly in areas prone to mold, such as basements or bathrooms.
Comparatively, bacterial spores exhibit even greater resilience, with some surviving extreme conditions like UV radiation, desiccation, and chemical disinfectants. *Clostridium botulinum* spores, for instance, can withstand boiling water for hours, only to revive when temperatures cool and nutrients become available. This makes them a persistent threat in food preservation, where improper canning techniques can leave spores dormant until consumption. To mitigate this, the USDA recommends processing low-acid foods at 240°F (116°C) for at least 30 minutes to ensure spore destruction, a critical step often overlooked in home canning.
The revival potential of dormant spores has profound implications for industries ranging from pharmaceuticals to space exploration. In medicine, understanding spore longevity is crucial for sterilizing medical equipment, as autoclaves must reach 121°C for 15–20 minutes to ensure complete spore inactivation. Conversely, in biotechnology, researchers harness this resilience, using spores as vectors for targeted drug delivery or environmental cleanup. For instance, *Bacillus subtilis* spores have been engineered to degrade oil spills, remaining dormant until they encounter hydrocarbons, at which point they activate and begin remediation.
In conclusion, the revival potential of dormant spores is a testament to their evolutionary ingenuity, offering both challenges and opportunities. By recognizing the specific conditions required for reactivation, we can develop strategies to control unwanted spore growth while leveraging their durability for innovative applications. Whether combating contamination or engineering solutions, understanding this delicate balance between dormancy and revival is essential for navigating the microscopic world of spores.
Exploring Non-Destructive Spore Drive Technology: Fact or Fiction?
You may want to see also
Frequently asked questions
Dry spores can survive in the environment for decades, even centuries, under favorable conditions such as low humidity, moderate temperatures, and minimal exposure to UV light.
While dry spores are highly resilient, their viability can decrease over time due to factors like prolonged exposure to harsh conditions, extreme temperatures, or chemical agents.
Dry spores can remain dormant for extremely long periods, but their ability to germinate eventually declines. However, under ideal conditions, they can retain viability for hundreds of years.
High humidity can reduce the lifespan of dry spores by promoting germination or degradation, while low humidity helps preserve their viability for extended periods.
Yes, dry spores can remain dangerous even after many years if they retain their viability. When conditions become favorable, they can germinate and cause infections or contamination.